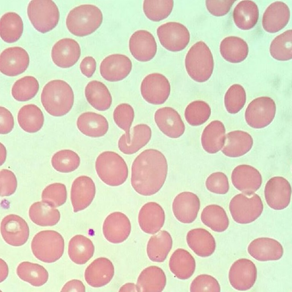

Menciona 3 objetos que se pueden desechar en el bote RBPI

1.-Agujas de jeringas desechables
2.-Navajas
3.-Lancetas
4.-Agujas de sutura
Llega contigo una paciente de 22 años que pesa 30 kg y mide 145cm, le tomas la siguiente química sanguínea ¿Algo te llama la atención?
Glucosa: 95 mg/dl
BUN:16
Cr:0.2
Colesterol total: 135mg/dl
Triglicéridos: 115 mg/dl
Tiene hipocreatininemia, el valor normal va de 0.6-1.2mg/dl, recuerda que la creatinina es un producto de desecho de la creatina que está en los músculos, por lo que puede indicar sarcopenia(PÉRDIDA DE MASA MUSCULAR)
¿Cual es el valor normal del volumen corpuscular medio?

80-100 fl

¿Cuál es el valor normal de la creatinina?
La creatinina normal depende el genero pero en general va de 0.7-1.2mg/dl
Llega un paciente de 60 años con diagnóstico de hipertensión, diabetes de larga evolución, y dislipidemia, las 3 comorbilidades sin control ya que no le gustan los medicamentos, llega a urgencias contigo por opresión torácica que se irradia a ambos brazos, como a la mandíbula de forma bilateral, se realiza un ECG con IAMCEST
¿Qué estudios de laboratorio indispensable le pides?
Biomarcadores cardiacos(Troponinas ultrasensibles)
¿Cómo se llama el aditivo que tiene el tubo lila y para que sirve?

EDTA( Etilendiamino-tetra-acetato)
Es un anticoagulante que se une a los iones de calcio
De la siguiente biometría hemática, responde las siguientes 4 preguntas:
¿Tiene anemia?
¿Si tiene anemia como la clasificas con el VCM y HCM?
¿Tiene algún otro trastorno en la fórmula roja?
¿Realmente tiene neutrofilia?
¿Tiene anemia? --> SI
¿Si tiene anemia como la clasificas con el VCM y HCM?
Macrocítica hipercrómica
¿Tiene algún otro trastorno en la fórmula roja?
Eritropenia de 2.66
¿Realmente tiene neutrofilia?
(Calcula lo neutrófilos absolutos)
(10,500)(93.90%) /100=9850
¿Cómo puedes calcular tu hematocrito con la Hb?
Resuelve lo siguiente:
Te traen una biometría hemática con hemoglobina de 13, pero salió ERROR en el Htco, como puedes calcularlo?
La formula para calcular el hematocrito con la hemoglobina es la siguiente:
Hb x 3= Htco
13 x 3= 39%
¿Cuál es el valor el valor de los tiempos de coagulación?
TP(Tiempo de protrombina):
TPT(Tiempo parcial de tromboplastina):
INR(Indice internacional normalizado):
TP(Tiempo de protrombina): 11-15 seg
TPT(Tiempo parcial de tromboplastina) 25-35 seg
INR(Indice internacional normalizado) 0.8-1.2
Llega contigo un paciente que ha vomitado 8 veces hoy y deposiciones diarreicas 10 veces Bristol 7, con tegumentos pálidos e hipotensión se le toma los siguientes electrolitos:
Na: 130
K: 4
Cl:100
Ca: 9
¿Tiene algún trastorno hidroelectrolítico?
Tiene hiponatremia hipovolémica
Estás en tu internado y vas a tomar una muestra a una paciente que tiene una mastectomía radical, pero te dice que no le piques del mismo lado, ¿Tiene razón? Si, no y por qué?
Si tiene razón, al realizar mastectomía retiras también ganglios linfáticos de la axila, por lo que se dificulta drenar la linfa, lo que puncionar podría causar acumulación de la misma lo que se llama LINFEDEMA

Llega contigo un paciente masculino de 77 años a urgencias por tos, disnea y fiebre de 38.9°C
1.-¿Calcula su Htco con solo la Hb, coincide con el resultado?
2.-Calcula los neutrófilos absolutos tu misma(o)
3.-¿Dame 2 causas de neutrofilia?
Llega contigo un paciente masculino de 77 años a urgencias por tos, disnea y fiebre de 38.9°C TRIADA NEUMONÍA
¿Calcula su Htco con solo la Hb, coincide con el resultado?
(Hb)x3=12.7x3=38.1%
Calcula los neutrófilos absolutos tu misma(o)
(10,590)(93.6)/100=9,912/uL
¿Dame 2 causas de neutrofilia?
Infecciones bacterianas y ejercicio intenso
¿Cómo puedo calcular los resultados de los leucocitos específicos como neutrófilos?
Ejemplo: Tengo 15,324 leucocitos y me reporta 60% de neutrófilos, ¿Cómo se cuantos son exactamente?
Neutrófilos absolutos: (Leucocitos totales)(Porcentaje de células) /100
Respuesta: (15,324)(60%)/100
919,440/100=9194.4 Neutrófilos absolutos
¿Cuál es el valor de reticulocitos para que una anemia sea arregenerativa o regenerativa?
Arregenerativas <2% donde la medula NO compensa
7.- Llega contigo un paciente de 75 años con alcoholismo crónico de 30 años, tiene el diagnóstico de cirrosis hepática, se le toman los siguientes estudios porque le realizaran una hernioplastia inguinal:
TP: 30 seg
TPT: 55 seg
INR: 2.2
¿Tiene algún trastorno y si si, por que crees que sea?
Tiene los tiempos de coagulación prolongados, es decir que tarda mas tiempo en formar un coágulo, esto causado por un daño al hígado, recordando que prácticamente todos los factores de coagulación se producen en el HIGADO
2790-->Dependiente de vitamina K

Mauricio tiene 41 años, tiene diabetes controlada sin daño a órgano blanco, le tomas un perfil lipídico con colesterol ldl de 200mg/dl, y un riesgo cardiovascular( de 15%, siendo un RCV alto, le quieres mandar estatinas para mejorar su control, pero el resi te pregunta cuales son las únicas 2 estatinas de alta intensidad?
Recuerda que las metas de tu ldl, dependen del riesgo cardiovascular, en este caso al ser >10% y <20%, la meta tiene que ser <70 mg/dl, para eso se necesita tto farmacológico con estatinas de alta intensidad:
-Atorvastatina 40-80 mg
-Rosuvastatina 20-40 mg

Alejandro llega a urgencias por una fractura de fémur con la siguiente biometría:
¿Cómo clasificamos su anemia con VCM y HCM?
Tiene plaquetas de 62 mil y le vas a transfundir un CP ,¿cuantas plaquetas estimas que subirá?
¿Tiene anisocitosis?¿Si,no por qué?
¿Cómo clasificamos su anemia con VCM y HCM?
Microcítica normocrómica
Tiene plaquetas de 62 mil y le vas a transfundir un CP,¿cuantas plaquetas estimas que subirá?
Por cada CP, sube aprox 10ml plaquetas
¿Tiene anisocitosis?¿Si,no por qué?
No, su RDW es <14.5%
Perla tiene 50 años, refiere poliuria, polidipsia, polifagia y pérdida de peso, sospechas de diabetes mellitus tipo 2, pero tu compa no recuerda los criterios de diagnóstico de diabetes tipo 2, solo recuerda que es ayuno, al azar y por hemoglobina glicada, recuérdale cuales son:
Glucosa en ayuno:
HbA1C:
Glucosa al azar o 2 horas postprandial:
Glucosa en ayuno: ≥126 mg/dl
HbA1C: ≥6.5%
Glucosa al azar o 2 horas postprandial: ≥200 mg/dl
Estás en tu consulta llega Omar de 65 años, fumador, diabético con PAS de 140 mmHg y con el colesterol total de 3 mmol/L(54 mg/dl), calcula su riesgo cardiovascular por GLOBORISK

El riesgo cardiovascular de Omar es de 22%, lo que es un riesgo muy alto
Se indica hipolipemiantes como:
-Estatinas
-Ezetimiba
-iPCSK9
2.-Una paciente de 17 años africana con desnutrición y sarcopenia desde el nacimiento por situación socioeconómica , tiene IMC de 15.4kg/m2, tiene anemia ferropénica, amenorrea y se le toma los la siguiente quimica sanguinea:
Glucosa en ayuno: 180 mg/dl
BUN: 17
Cr.0.3
Colesterol 127 mg/dl
Triglicéridos: 55 mg/dl
Aparte de hipocreatininemia por la sarcopenia, tiene muy probable diabetes tipo 5 por la desnutrición en la infancia y la actual
¿Cuáles son las 4 hormonas/sustancias contrarreguladoras de la insulina?
1.-Glucagón
2.-GH(Hormona del crecimiento)
3.-Cortisol
4.-Catecolaminas
COMBO DE PREGUNTAS
1.-¿Cuál es la técnica correcto para la toma de un urocultivo por sonda y a chorro medio?
2.-¿Qué piensas si en un EGO salen nitritos y esterasa leucocitaria?
3.-Interpreta el siguiente EGO
Tecnica de chorro medio:

Técnica por sonda vesical

Llega Margarita a urgencias contigo por un dolor en hipocondrio derecho, con fiebre 38.5°C, con leucocitosis de 23 mil, neutrofilia de 10ml/campo, se le realizó un USG de hígado y vía biliares con grosor de vesícula de 6mm, diagnosticando colecistitis aguda, que posteriormente progresa a coledocolitiasis se le realiza el siguiente perfil de funcionamiento hepático.
Calcula el factor R:
BT: 2.1
BD: 1.3
BI: 0.75
AST: 198
ALT: 350 (7-52 UI/L)
Fosfatasa alcalina: 820 (34-104 UI/L)
Calcula el factor R:
BT: 2.1
BD: 1.3
BI: 0.75
AST: 198
ALT: 350 7-52 UI/L
Fosfatasa alcalina: 820 34-104 UI/L
CALCULO
ALT del paciente (350)/Límite superior(52UI/L) = 6.7
FA del paciente(820)/Límite superior(104UI/L)
=7.8
Factor R: 6.7/7.8= 0.85 Patrón colestásico <2
Leslie es una paciente de 43 años, que sus padres y abuelos tienen diabetes, ella presenta acantosis nigricans y acrocordamos laxos no tiene criterios de diabetes pero tampoco están normales, ¿Cuáles son criterios para diagnosticar diabetes?
1.-Glucosa en ayuno:
2.-Glucosa postprandial o al azar:
3.-Hb1AC:

1.-Glucosa en ayuno: 101-125mg/dl
2.-Glucosa postprandial o al azar: 140-199mg/dl
3.-Hb1AC: 5.7-6.4%
Llega contigo a tu consulta Marco de 62 años quien tiene ERC, tuvo cirugía de cuello que retiraron glándulas paratiroides, tiene sintomatología muy heterogénea, neuropsiquiátrica, gastrointestinal pero tiene 2 hallazgos característicos:
1.-Al percutir en su cara delante de la oreja su cara responde moviéndose
2.-Al tomarle la TA, su brazo comenzó a doblarse hacia adentro
Trae los siguientes laboratorios:
Na: 139 6mEq/L
K:4.1 6mEq/L
Cl:101 6mEq/L
Ca: 6mEq/L
Responde estas 2 preguntas:
1.-¿Cuál es tu sospecha clínico?
2.-¿Como se les llama a los 2 signos que presenta Marco
Marco tiene hipocalcemia clínico secundaria a su ERC y su hipoparatiroidismo
Los signos encontrados fueron:
-Signo de Chvostek: Hiperexcitabilidad del nervio facial
-Signo de Trosseau: Hiperexcitabilidad + isquemia